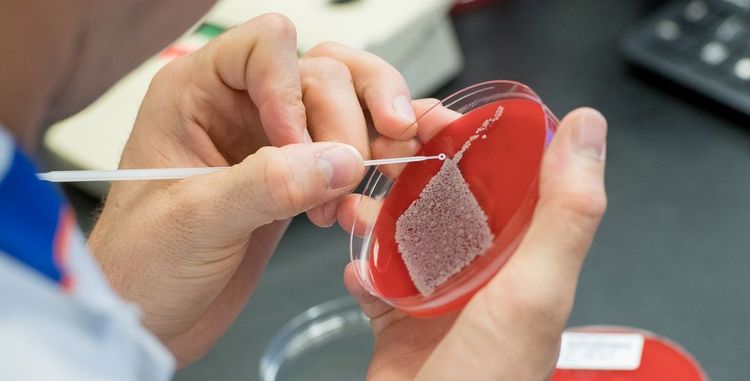

Forschung
Kontakt
Prodekanin für Forschung und Groningen
Bereichsleitung Forschung, wissenschaftliche Karriereförderung und Internationales
Weiterführende Links
Forschung
Die Carl von Ossietzky Universität Oldenburg und die Rijksuniversiteit Groningen verbindet seit über 40 Jahren eine intensive Kooperation. Zahlreiche wissenschaftliche Projekte wurden bereits gemeinsam realisiert. Hervorzuheben ist z.B. das von 1999-2009 von der DFG und NWO geförderte internationale Graduiertenkolleg „Neurosensory Science, Systems and Applications“. Seit der Gründung der Universitätsmedizin Oldenburg im Jahr 2012 werden grenzüberschreitende Forschungsaktivitäten im Bereich der Medizin und Gesundheitswissenschaften nun noch stärker gebündelt.
Projektauswahl
Zahlreiche weitere Forschungskooperationen konnten bereits realisiert werden (u.a. gefördert durch: das Marie Skłodowska-Curie-Programm, INTERREG, die DFG und das MWK), weitere sind in Planung. Hierfür haben die Oldenburger und Groninger Wissenschaftler*innen auch die Möglichkeit, Gelder aus dem „Forschungspool“ der Fakultät für Medizin und Gesundheitswissenschaften zu beantragen.
Des Weiteren bündeln Oldenburger und Groninger Wissenschaftler*innen ihre Expertise, um gemeinsame Veranstaltungen für Wissenschaftler*innen in der frühen Karrierephase und Studierende anzubieten.
Cross-Border Institute
In 2018 fiel auch der Startschuss für die Gründung des Cross-Border Institute of Healthcare Systems and Prevention. In diesem Gemeinschaftsprojekt bündeln das Oldenburger Department für Versorgungsforschung und die Groninger Aletta Jacobs School of Public Health ihre Kompetenzen, um das niederländische und das deutsche Gesundheitssystem aus unterschiedlichen Blickwinkeln zu beleuchten.
Joint MD/PhD Programm
Seit 2023 bietet das Programm jährlich motivierten und forschungsbegeisterten Medizinstudierenden aus Groningen und aus Deutschland die Möglichkeit eines Joint MD/PhD in Groningen und Oldenburg. Die Geförderten forschen nicht nur an beiden Standorten, sie lernen auch das andere Gesundheitssystem kennen, belegen Kurse beider Graduiertenschulen und profitieren vom internationalen Arbeitsumfeld und erwerben interkulturelle Kompetenzen. Das Programm ist Teil des Programms zur wissenschaftlichen Karriereförderung in der frühen Phase ein erster Schritt auf dem Weg zu einer Beschäftigung als Clinician Scientist.
Joint Graduate Research Training Group
In 2018 starteten die ersten Promovierenden des deutsch-niederländischen Promotionsprogramms „Translational Research: From Pathological Mechanisms to Therapy". Ziel des interdisziplinär ausgerichteten Programms ist es, Grundlagenforschung, klinische Forschung und bevölkerungsbezogene Forschung zu verzahnen, um bessere Behandlungserfolge zu erzielen und den Gesundheitszustand und die allgemeine Lebensqualität der Patient*innen zu verbessern. Die Promovierenden werden jeweils von einem Team aus renommierten deutschen und niederländischen Wissenschaftler*innen betreut und verbringen ihre Forschungszeit alternierend an beiden Standorten.

